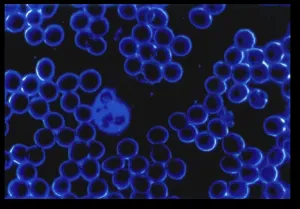

|
|
Some Amazing
information and Facts on PEMF
Pulsed
Electro-magnetic Field
Therapy
|
|
You are only as healthy as your cells...
By simple exposure of the body to pulsated low frequency
magnetic fields stimulate cell metabolism, increase oxygen assimilation,
and accelerate the
removal of toxic chemicals and waste.PEMF, Pulsating electromagnetic fields
can fully penetrate the body and reinforce weak functional cycles
in a natural
way. This allows the body to recover its self-healing capabilities. As a
result, health and wellness improves.

Just imagine, reaching into the body and healing
an imbalance without touching anything. This is what PEMF,s can
do. This is the essence of
energy medicine. These magnetic “waves” are the future medicine.
Magnetic field devices becoming available to the public deliver fields
to the body that are “like a breeze in the trees”. The branches
and leaves are moving but nothing is seen to be doing it. This “air” moves
through the body like it wasn’t even there. This is the magic potential
of pulsed electro magnetic fields.
| "All living cells within the body possess potentials
between the inner and outer membrane of the cell, which,
under normal
healthy circumstances, are fixed. Different cells, e.g. Muscle
cells and Nerve cells, have different potentials of about -70
mV respectively. When cells are damaged, these potentials change
such that the balance across the membrane changes, causing
the attraction of positive sodium ions into the cell and negative
trace elements and proteins out of the cell. The net result
is that liquid is attracted into the interstitial area and
swelling or edema ensues. The application of pulsed magnetic
fields has, through research findings, been shown to help the
body to restore normal potentials at an accelerated rate, thus
aiding the healing of most wounds and reducing swelling faster.
The most effective frequencies found by researchers so far,
are very low frequency pulses of a 7bpm base. These, if gradually
increased to 9 ppm for time periods of 600 seconds
(10 minutes), condition the damaged tissue to aid the natural
healing process." Based on the findings of Dr. D. C. Laycock,
Ph.D. Med. Eng. MBES, MIPEM |
Specific
Medical PEMF Applications A-M
Specific Medical PEMF Applications N-Z
What is aPEMF, Pulsating
electromagnetic fieldss?
Have you have ever held two magnets in your hands,and tried to
force them together, and felt a resistance between them, if so
you have
experienced magnetic fields. The Earth has its own magnetic field,
produced by changes in the molten core of the planet.
The presence of this field causes a compass to rotate so
that the north pole of the compass points north. An electromagnetic
field is a field produced by moving
electrical charges. It affects any other
objects in the range of the field.This is a natural
activity in the universe.

"PEMF stands for Pulsed ElectroMagnetic Fields, which
are widely used these days to improve circulation and cell metabolism.
The
body can become accustomed to nonmoving (or static) magnetic fields,
which are generally unable to deeply penetrate the body. A pulsed
electromagnetic field, however, is dynamic, is able to penetrate
all the way through the body, and creates a cascade of effects
within the body."
| Alzheimer's Disease
After applying external electromagnetic fields
ranging 5 to 8 Hz, large improvements were detected in
Alzheimer's
patients. These included improved visual memory, drawing
performance, spatial orientation, mood, short-term memory
and social interactions. Ref R. Sandyk, "Alzheimer's
Disease: Improvement of Visual Memory and Visuoconstructive
Performance Treatment with Picotesla Range Magnetic Fields," International
Journal of Neurosci.
Alzheimer's Disease
R. Sandyk: 'Alzheimer's Disease: Improvement of Visual Memory
and Visuoconstructive Performance by Treatment with low intensity
PEMF in Picotesla intensity ' International Journal of Neuroscience,
76 (3-4),
Two Alzheimer's patients showed a definite improvement after
treatment with PEMF, especially in the visual memory and
their drawing abilities. There were also improvements in
other cognitive functions, in the ability of these patients
to orient themselves in space, their mental/emotional condition,
their ability to make social contact and their short-term
memory. Neuropsychologia. 2003;41(8):952-67
R. Sandyk et al.: ' |
How ectromagnetic fields Can effect my body?
We now understand, an electromagnetic field affects the behavior
of anything withn the vicinity of the field. Every heartbeat
generates electromagnetic waves throughout the blood vessels
of the body, stimulating tissues
at a cellular level. External magnetic fields and the normal
electric and electromagnetic fields produced by the body interact.
So, a magnetic field passing through our whole body will have
an electromagnetic effect on each of our 70 trillion cells. As
a result, magnetic fields act in basic and fundamental ways on
molecules and tissues. They affect the most basic functions of
all cells—human, animal, and plant included.
ARTICLES INDICATING more specific APPLICATIONS
OF THE PEMF ELECTROTHERAPEUTIC GENERATORS

Parasystolic Arrhythmia
Noninvasive low-frequency electromagnetic stimulation of the
left stellate ganglion reduces myocardial infarction-induced
ventricular
arrhythmia. Source
The use of low-level electromagnetic fields to suppress atrial
fibrillation Source
What are some basic cell functions, and how do magnetic fields
help?
Basic actions of a cell are
1 generate energy / eliminate
waste,
2 repair and regeneration,
3
perform its
functions based on the cell’s type and location
.Magnetic fields cause or increase motion of ions and electrolytes
in the tissues and fluids of the body. It’s both easy and
quick to move an ion or electrolyte in a living organism using
magnetic fields. This movement stimulates a vast array of chemical
and electric actions in the tissues of the body, helping them to
rebalance or heal themselves where necessary.
Improved Circulation
- Circulatory problems: in vascular disease caused by diabetes
and sclerosis (arteriosclerosis), in varicose veins with
ulcers
- Accelerated absorption of bruises (haematomas)
- Expulsion of lymph oedema
Can Rife machine induced PEMF work on
Diabetic ulcers ? The large ulcer on the side of the leg had
resisted conventional treatment for two years Treatment continued
Daily with the Rife Pro systemt and the small Magnacoil Warning
these graphic pictures may disturb some people Look
here
https://altered-states.net/barry/newsletter221/ |
Heart Disease More here
All cells need energy to function. Cellular energy requires ATP
(Adenosine Triphosphate) and is fundamental to all cell and body
functions and is necessary to sustain life itself. ATP regulates
cell metabolism by transporting chemical energy within our cells.
Low ATP levels cause our cells to be sick, and decreases their
ability to heal, regenerate, or function properly. Through the
increased motion of ions and electrolytes, magnetic fields help
cells increase their energy (or “charge”) by up to
500%.
Headaches
Two previous studies had found that electro-magnetic
fields (EMFs) reduce pain and swelling. EMFs also have
that effect
in a new trial headed by orthopedic surgeon Roy K. Aaron.
Presumably, he says, it does it "by changing the chemistry of the
joint." Studies by his team and others indicate that
these fields can increase a joint's production of natural
anti-inflammatory
agents, such as transforming growth factor-beta. Not surprisingly,
Aaron notes, medical supply companies are now developing
products, such as a glove with coils, to deliver EMFs to
arthritis-savaged
joints. Softer tissues also respond to these fields. For
instance, Arthur A. Pilla, a biophysicist at the Mount Sinai
School of
Medicine in New York City, observes that many people with
bone breaks experience significant pain in muscles around
their
injuries. Shortly after EMF therapy begins, however, that
pain disappears.
Health Effects of Electro-Magnetic Fields
from Science News, Vol. 156, No. 20 |
How PEMF Heals the Body >>>more
here
How PEMF affects Cancer Cells>>>more
here
Specific Medical PEMF Applications >>>more
here
Why I need treatment at a cellular level?
Magnetic fields also affect the charge of the cell membrane, which
allows membrane channels to open up. These channels are like
the doors and windows your car. Opening cell channels(like car
windows), encourges nutrients to enter the cell, and waste(as
in car fumes)is
more easily eliminated
. This helps rebalance and restore optimum cell
function. Bringing cells back to their optimum level means
they will all work more efficiently. Cells of the same
type come
together
to
make
tissues,
and those tissues come together to make organs. By restoring
or maintaining cellular function, you will restore
AND maintain organ function. This allows the entire body to
function better. Maintaining
the function of every individual cell at an optimal level every
day is an important part of slowing aging.

What long term benefits
come from PEMF, Pulsating electromagnetic fields therapy ?
Cellular “injury”, when a cell is not
healthy, leads to disease conditions. Magnetic fields protect against
cell injury by improving circulation, repair processes, and energy,
and increasing stress proteins in the cells. These proteins
are used to prevent cell breakdown and wear and tear, as well as
help speed recovery from injury. Magnetic fields balance cells,
tissues and bodily functions at very fundamental levels, even before
damage and problems become obvious to you.
Abstract
A body part of an animal afflicted with malignant cells is
disposed within a magnetic coil and subjected to a plurality
of magnetic field pulses, the pulses having intensities of
between about l and about 100 Tesla and characteristic frequencies
of between about 5 and about 100 kHz. The pulses magnetic
field selectively inactivates and/or destroys malignant cells
with relatively little damage to normal tissue.
Summary of the Invention
... Herein, it is discovered that high intensity magnetic
fields applied in short pulses with moderate frequencies,
can be used to selectively destroy or otherwise inactivate
malignant cells within tissue of a living animal. Selective
inactivation of malignant cells within animal tissue
subjected to a pulsed magnetic field is accomplished
without noticeable deterioration of gross characteristics
of normal tissue. Jonathan L. Costa, Gunter A. Hofmann
The Rife pro unit uses Magnacoils pulsed at rife frequencies |
Cardio Vascular Diseases: Let us see how PEMF can
be used for the prevention of Heart Attack. In hypertensive people
the blood cholesterol level is reduced. Centrally mediated vascular
dilatation also helps in the reduction of blood pressure. Increases
the circulation of blood in all the blood vessels. This helps to
increase the supply of nutrition to all the tissues of the body
and also prevents platelet aggregation. Some studies conducted
in Russia shows that the thickening of the blood vessels can be
reduced in atherosclerotic condition due to the disintegration
of plaques. PEMF has a peculiar property of blocking the oxygen
free radicals which are responsible for cadic cell damage. All
this contribute to prevention of block in coronary arteries which
supplies blood to heart, and there by prevents heart attack. Other
vascular conditions in which PEMF is effective are PHLEBITIS, ENDARTERITIS,
VARICOSE VEIN etc. Source
How CAN I use PEMF?
Magnetic fields selected for treatment support health
maintenance, PEMF, Pulsating electromagnetic fieldss used in
the home daily would be an important part of any holistic maintenance
program, in addition to any other program. Magnetic therapies
are usually complementary to other therapies, and they usually
enhance each other’s benefits.
"Detailed Description of a Preferred Embodiment
It is found that subjecting body parts containing cancerous
tissue to a plurality of magnetic field pulses, with characteristic
frequencies above about 5 kHz and intensities above about
1 Tesla, will either arrest the growth of tumors or progressively
reduce the number of cancerous cells, resulting in remission
of tumors...
Malignant cells are more susceptible to destruction and/or
inactivation by a pulsed intense electromagnetic field because
the field may create eddy currents that are unique to the tumor.
These localized eddy currents may cause effects that are deleterious
to the viability and/or reproductive capability of the tumor
cells. Alternatively, there may be macromolecules unique to
malignant cells which are especially magnetically susceptible...
Furthermore, treatment with a pulsed magnetic field does far
less damage to the natural immune system than does radiation
treatment or chemotherapy. Frequently, a patient who is treated
extensively with ionizing radiation and/or with chemotherapy
will experience an almost complete breakdown of the immune
system. Subsequent to treatment, the immune system may take
up to a year to recover, particularly with respect to immunity
to viral infections. As a result, even if a patient is cured
of the malignancy by radiation and/or chemotherapy, he is subject
to debilitating disease or even death by infections to which
his body would ordinarily have built up immunity. With the
magnetic treatment described herein, here has been no evidence
of major immune system beak-down. " |
Ways to enhance the
beneficial affects of PEMF, Pulsed electromagnetic fieldss?
Since most of the effects of magnetic fields happen because of
how they act on ions, especially calcium, sodium, potassium,
and magnesium, these ions and electrolytes need to be at the
right levels in the body. It is difficult to heal depleted tissues
without sound nutrition. Supplements may also be quite helpful
for magnetic therapy to be most effective. Magnesium supplementation
and adequate amounts of daily water are encouraged.. Additionally,
some individuals (particularly women)
need extra melatonin to optimize health while using PEMF, Pulsed electromagnetic fieldss
.
Beneficial effects PEMF, Pulsed electromagnetic fieldss have
in my body?
Increased Circulation
 |
One of the most basic functions magnetic
fields have in the body is to increase circulation. When
a cell (such as a red
blood cell) is injured or ill, it does not hold its ideal
charge. This causes red cells to “stick” together,
making circulation slow. When a magnetic field passes through
the
red cell, the membrane becomes properly charged, allowing
the cell to repel itself and keep itself separate from other
red
cells, thereby increasing circulation. In addition, PEMF, Pulsed electromagnetic fieldss
increase various chemicals in the blood vessel walls that
cause the
blood vessels to dilate, improving the amount of blood flowing
through the vessels and therefore increasing the amount of
oxygen delivered to the tissues |
Poor circulation makes tissues unhealthy and prone to disease
and breakdown. Improved circulation helps tissues get the nutrition
and oxygen they need, while expelling the waste they produce. Good
circulation helps with tissue healing and regeneration. The result
of improved circulation is the reduction of swelling and the removal
of bruising.
Enhanced Muscle Function
Muscle energy, needed for muscles to work, is developed through
a process called Myosin Phosphorylation. Myosin is muscle, and
phosphorylation is energy (ATP) production. Optimal energy allows
muscles to work harder and longer, and recover more quickly from
their work. Muscles that are contracted or in spasm are better
able to relax, decreasing tension and reducing the pain caused
by spasm.

Decreased Inflammation
Inflammation is a process initiated by
the body to repair cellular damage in tissues by increasing the
blood flow to the damaged area and increasing the number of good
inflammatory cells. The process of inflammation is generated
and supported by the interaction of a number of immune cell types,
with other cell types (like T cells) playing a regulatory role.
Inflammation is a necessary and beneficial process, but it often
persists longer than necessary, causing chronic inflammation.
Chronic inflammation is frequently a cause of chronic pain. PEMF, Pulsed electromagnetic fieldss
have been found to reduce chronic,
damaging inflammation. Inflammation can be initiated by many
causes.

What are SYMPTOMS of CHRONIC INFLAMMATION?
1.bloating & passing gas
2.belching
3.burning skin
4.dark circles and bags under the eyes
5.itchy ears and eyes
6.diarrhea
7.constipation
8.cramping
9.joint pain or stiffness
10.muscle spasms, twitching
|
11.fatigue
12.memory problems
13.rash, hives, acne, cysts, boils
14.scaly, rough skin
15.cough or sore throat
16.stuffy nose or runny nose
17.loss of appetite
18.fever or chills
19.headache
20.puffiness, edema, water retention
|
T cells are a major regulator of the inflammatory cycle. In
bacterial infections, early infiltration of the affected tissues
by white blood cells is followed by the arrival of T cells, which
kill bacteria. In this circumstance, elimination of T cells can
delay or stop healing. In trauma-induced injury, T
cells are less important to the healing process, and may be harmful
if present for too long. In this case, elimination of T cells can
minimize the unwanted effects of inflammation, accelerate healing,
and reduce the risk of chronic inflammatory diseases.

Research shows us that PEMF, Pulsed electromagnetic fieldss can induce the appropriate death
of aged, chronic T lymphocytes, by actions on T cell membranes
and key enzymes in cells. For example, PEMF, Pulsed electromagnetic fieldss affect ion flow through
specific cell membrane channels (like those for sodium, potassium,
and calcium), which positively affect these enzymes.

Stress Reduction
Stress is part of being human. Normal stress
is necessary for survival. Too much stress is very harmful to
the body, and accelerates aging. Stress is responsible for at
least 75% of our illnesses, so stress reduction is necessary
for all of us. Magnetic fields have many stress-reducing effects.
Daily use of PEMF, Pulsed electromagnetic fieldss help to wash away the negative effect natural
stresses
have on our bodies.

Bone Healing
Magnetic fields pass right through the entire body PEMF, Pulsed electromagnetic fieldss work
to repair bones, whether they are damaged by surgery, injury,
or disease,
and have
been found to improve bone regeneration such as occurs with osteoporosis
, and other bone destroying conditions.

Finger Tip Oximeter
Blood Oxygenation
Just as a fire cannot burn without oxygen, our cells cannot produce
heat and energy without oxygen. . It passes into our blood and
is carried by arteries away from the heart and delivered to the
rest of the
body, including all the organs. PEMF, Pulsed electromagnetic fieldss help with the process of
extracting oxygen out of the air we breathe and help it to be
transported into the circulation. The absorbed oxygen is then
transported through the body to all the cells. In the cells,
enzymes and other basic cell energy uses
the oxygen for cell metabolism,
the energy necessary to function properly. The metabolism of
an organism determines which substances it will find nutritious
and which it will find harmful. Proper blood-oxygen levels at
the cell level allow this process to
continue quickly and efficiently. After the oxygen exchange takes
place, veins carry deoxygenated blood and metabolic waste products
away from those same cells and back to the heart for recycling
again.
Paracetamol No Better than Placebo for Low Back Pain, Study
Finds
(Reuters) – Paracetamol, a painkiller
universally recommended to treat people with acute low
back pain, does not speed recovery
or reduce pain from the condition, according to the results
of a large trial published on Thursday.
A study published in The Lancet medical journal found that
the popular pain medicine was no better than placebo, or
dummy pills, for hastening recovery from acute bouts of low
back pain or easing pain levels, function, sleep or quality
of life.
Researchers said the findings challenge the universal endorsement
of paracetamol as the first choice painkiller for lower back
pain.
“We need to reconsider the universal recommendation
to provide paracetamol as a first-line treatment,” said
Christopher Williams, who led the study at the University
of Sydney in Australia. |
We hope this helps provide a basic understanding
of how magnetic fields, especially PEMF, Pulsed electromagnetic fieldss, work in the body. In
addition to these basic balancing actions, magnetic fields also
help with many other functions and conditions, and new ones are
discovered regularly.
Some of these other actions include:
• reducing muscle tension
• improving tissue healing
• reducing pain
• increasing energy
• improving clotting factors
• slowing the development of arthritis
• stimulating the immune system
• helping the body to detoxify
• improving the uptake of nutrients
• reducing blood pressure
• helping nerve function
• helping liver function
• balancing the acupuncture meridians
• improving sleep
• making soft tissue more flexible
• reducing arthritic changes
Specific
Medical PEMF Applications A-M
Specific
Medical PEMF Applications N-Z
Dark Field Microscopy before and after PEMF, Pulsed electromagnetic fields treatment

Before exposing to PEMF, Pulsed electromagnetic fields Therapy |
8 minutes after exposing to PEMF, Pulsed electromagnetic fields |
The
Effects of Pulsed Electromagnetic Fields (PEMF) on
| "By exposing the damaged tissue or scar tissue to repeated
pulsed magnetic fields for approximately 5 to 15 minutes
varying from twice a day several hours apart to once every
other day for approximately one to several weeks much of
the damaged tissue or scar tissue, judging from empirical
field usage results, can apparently be repaired/removed and
be replaced with normal healthy tissue." |
"Electromagnetic-field therapy method and device
Pulsed [electromagnetic] field therapy produces a complex effect
on the living organism, because it contributes to an improvement
in the energy metabolism, increases the mobility of lymph, enhances
the blood supply of capillaries, and, as a consequence, improves
nutrition of all tissues of the organism. The pulse field therapy
liquidates stagnation of energy in tissues, whereby painful sensations
are eliminated. The pulse therapy improves ion exchange on the
level of cells, regulates the intracellular pressure, this contributing
to normalization of the overall metabolism. "
The really good news with
this therapy is that a device like the PEMF-Pulser
is designed to also focus the energy
field where the body needs healing the most.
PEMF Pulser

"If you have a pacemaker, or a Cochlear hearing
implant, you cannot use the MAGNETIC PULSER for fear of
destroying their electrical circuits.Hearing aids can be removed
and placed at least ten feet away from the treatment area"
Rife Machines
with PEMF Pulsed electromagnetic field therapy
Source:
|